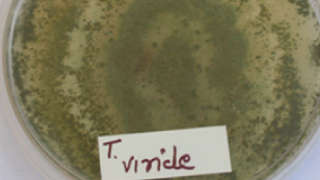

जैविक शेतीअॅग्रोस्टार अॅग्रोनॉमी सेंटर ऑफ एक्सीलेंस
बुरशीजन्य रोगांच्या नियंत्रणासाठी ट्रायकोडर्मा योग्य जैविक पर्याय
ट्रायकोडर्मा ही एक उपयुक्त बुरशी असून, सेंद्रिय पदार्थांच्या सान्निध्यात चांगल्या प्रकारे वाढते. ही बुरशी मातीमध्ये वाढणारी, परोपजीवी तसेच इतर रोगकारक बुरशींवर जगणारी आहे. या बुरशीच्या ७० च्या आसपास प्रजाती आढळतात. त्यापैकी ट्रायकोडर्मा व्हीरीडी, ट्रायकोडर्मा हरजानियम या मोठ्या प्रमाणात जैविक नियंत्रणात वापरल्या जातात. पावडर, द्र्व स्वरुपात ट्रायकोडर्मा बाजारात उपलब्ध आहे. या उपलब्ध फ़ॉरम्युलेशन्सचा वापर एकात्मिक रोग व्यवस्थापनामध्ये पीक लागवडीपासून बीज प्रक्रिया, आळवणी, शेणखत, सेंद्रिय खते, स्लरी तसेच ठिबक सिंचनाद्वारे देखील करता येतो.
सध्याच्या कालावधीमध्ये सर्वत्र पेरणी, भाजीपाला पीक लागवडीचा हंगाम सुरु होत आहे. शेतीमध्ये जमिनीद्वारे, बियांमार्फत पसरणाऱ्या रोगांच्या नियंत्रणासाठी जमिनीत बियाणे व रोपांच्या मुळांच्या सान्निध्यात रासायनिक बुरशीनाशकांचा वापर करावा लागतो. परंतु जमिनीत रासायनिक बुरशीनाशकांची कार्यक्षमता जास्त काळ टिकून राहत नाही तसेच त्यामुळे जमिनीतील सूक्ष्मजिवांच्या कार्यक्षमतेवरदेखील विपरीत परिणाम होतो. सेंद्रिय पीक पद्धतीमध्ये ट्रायकोडर्मा ही बुरशी मोठ्या प्रमाणात वापरली जाते. बदलत्या हवामान, पीक पद्धत व वाढत्या रासायनिक घटकांच्या वापरामुळे जमिनीतील रोगकारक बुरशींची संख्या दिवसेंदिवस वाढत आहे आणि उपयुक्त बुरशींची संख्या कमी होत आहे. बऱ्याच वेळा रासायनिक बुरशीनाशके वापरून देखील अपेक्षित परिणाम मिळत नाही.
ट्रायकोडर्माचा वापर -
१) प्रयोगशाळेत ट्रायकोडर्मा द्रव व भुकटी स्वरूपात तयार केली जाते. जास्त करून पावडर स्वरूपातील उत्पादने मातीमध्ये शेण खत व सेंद्रिय खतातून मोठ्या प्रमाणात वापरली जातात; तसेच पाण्याद्वारे देखील ठिबक सिंचनातून जमिनीत देता येते. रोपांची पुर्नलागवड करतेवेळी ट्रायकोडर्माच्या द्रावणात बुडवून मगच लावावीत.
२) बीजप्रक्रिया करताना ट्रायकोडर्माची भुकटी एक किलो बियाण्यास ५ ग्रॅम या प्रमाणात चोळावी. डाळिंबामध्ये ठिबकखाली ५० ते १०० ग्रॅम पावडर शेणखत, सेंद्रिय खत, निंबोळी पेंड यांच्यासोबत मिसळून टाकावी. शेडनेटमध्ये बेड भरताना ट्रायकोडर्मा १० ते १५ ग्रॅम प्रति चौ. मीटर या प्रमाणात टाकावे. ओलावा उपलब्ध असताना सेंद्रिय पदार्थात, शेणखतात ट्रायकोडर्मा अधिक चांगल्या प्रकारे वाढते. सेंद्रिय पदार्थांचा जमिनीतील वापर वाढविल्यास ट्रायकोडर्मा वाढीसाठी अनुकूल वातावरण तयार होते. गांडूळ खत वापरताना त्यामध्ये ट्रायकोडर्मा भुकटी मिसळून घ्यावी. जमिनीचा सामू (पी.एच.) हा ६.५ ते ७.५ च्या दरम्यान असल्यास ट्रायकोडर्माचा परिणाम चांगल्या प्रकारे मिळतो.
३) साधारणपणे १०० किलो चांगल्यापैकी कुजलेल्या शेणखतात २ किलो ट्रायकोडर्मा भुकटी मिसळून घ्यावी, असे मिश्रण शेतीमध्ये पेरणीपूर्वी वापरता येते. कांदा पिकात होणारी पांढरी सड, तळकुजव्या रोग, मर रोग इत्यादी रोगांच्या नियंत्रणासाठी ट्रायकोडर्मा भुकटी रोपे टाकण्यापूर्वी व रोपे लागवडीपूर्वी मुख्य शेतात मिसळून घ्यावी.
४) रोपवाटिकेत ट्रायकोडर्मा भुकटीचा वापर जास्त प्रमाणात केल्यास रोपांची रोपावस्थेत, पुर्नलागवडीनंतर होणारी मर थांबवता येते. भाजीपाला पिकांच्या रोपांची पुर्नलागवड झाल्यानंतर रोपांच्या मुळांच्या कार्यक्षेत्रात ट्रायकोडर्माची आळवणी करून घ्यावी त्यामुळे मर (डॅम्पिंग ऑफ) रोगाचा प्रादुर्भाव थांबवता येईल.
५) ट्रायकोडर्माचा वापर करण्यापूर्वी व केल्यानंतर १५ दिवसांपर्यंत रासायनिक बुरशीनाशकांचा वापर थांबवावा त्यामुळे ट्रायकोडर्माचा परिणाम चांगला मिळतो. पानांवरील रोगकारक बुरशींच्या नियंत्रणासाठी देखील ट्रायकोडर्माची फवारणी फायदेशीर ठरते आहे; परंतु त्यासाठी बुरशीच्या वाढीसाठी अनुकूल वातावरण शेतात उपलब्ध असणे आवश्यक असते.
संदर्भ – सहायक प्राध्यापक श्री.तुषार उगले (के.के.वाघ कृषी महाविदयालय, नाशिक)
जर आपल्याला ही माहिती उपयुक्त वाटली, तर फोटोखाली दिलेल्या पिवळया अंगठयाच्या चिन्हावर क्लिक करा आणि खाली दिलेल्या पर्यायच्या माध्यमातून आपल्या सर्व शेतकरी मित्रांसोबत शेयर करा!
157
2

